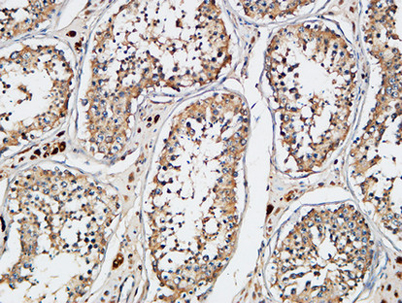

XIAP rabbit pAb
 One-click to copy product information
One-click to copy product information| 50 µL | $148.00 |
| 100 µL | $248.00 |
Overview
-
 Western Blot analysis of various cells using XIAP Polyclonal Antibody diluted at 1:1000. Secondary antibody(catalog#:RS0002) was diluted at 1:20000
Western Blot analysis of various cells using XIAP Polyclonal Antibody diluted at 1:1000. Secondary antibody(catalog#:RS0002) was diluted at 1:20000 -
 Western Blot analysis of 293 cells using XIAP Polyclonal Antibody diluted at 1:1000. Secondary antibody(catalog#:RS0002) was diluted at 1:20000
Western Blot analysis of 293 cells using XIAP Polyclonal Antibody diluted at 1:1000. Secondary antibody(catalog#:RS0002) was diluted at 1:20000 -
 Immunohistochemical analysis of paraffin-embedded Human testis. 1, Antibody was diluted at 1:200(4° overnight). 2, High-pressure and temperature EDTA, pH8.0 was used for antigen retrieval. 3,Secondary antibody was diluted at 1:200(room temperature, 30min
Immunohistochemical analysis of paraffin-embedded Human testis. 1, Antibody was diluted at 1:200(4° overnight). 2, High-pressure and temperature EDTA, pH8.0 was used for antigen retrieval. 3,Secondary antibody was diluted at 1:200(room temperature, 30min -
Immunohistochemical analysis of paraffin-embedded Human testis. 1, Antibody was diluted at 1:200(4° overnight). 2, High-pressure and temperature EDTA, pH8.0 was used for antigen retrieval. 3,Secondary antibody was diluted at 1:200(room temperature, 30min
Immunohistochemical analysis of paraffin-embedded Human testis. 1, Antibody was diluted at 1:200(4° overnight). 2, High-pressure and temperature EDTA, pH8.0 was used for antigen retrieval. 3,Secondary antibody was diluted at 1:200(room temperature, 30min


 Manual
Manual